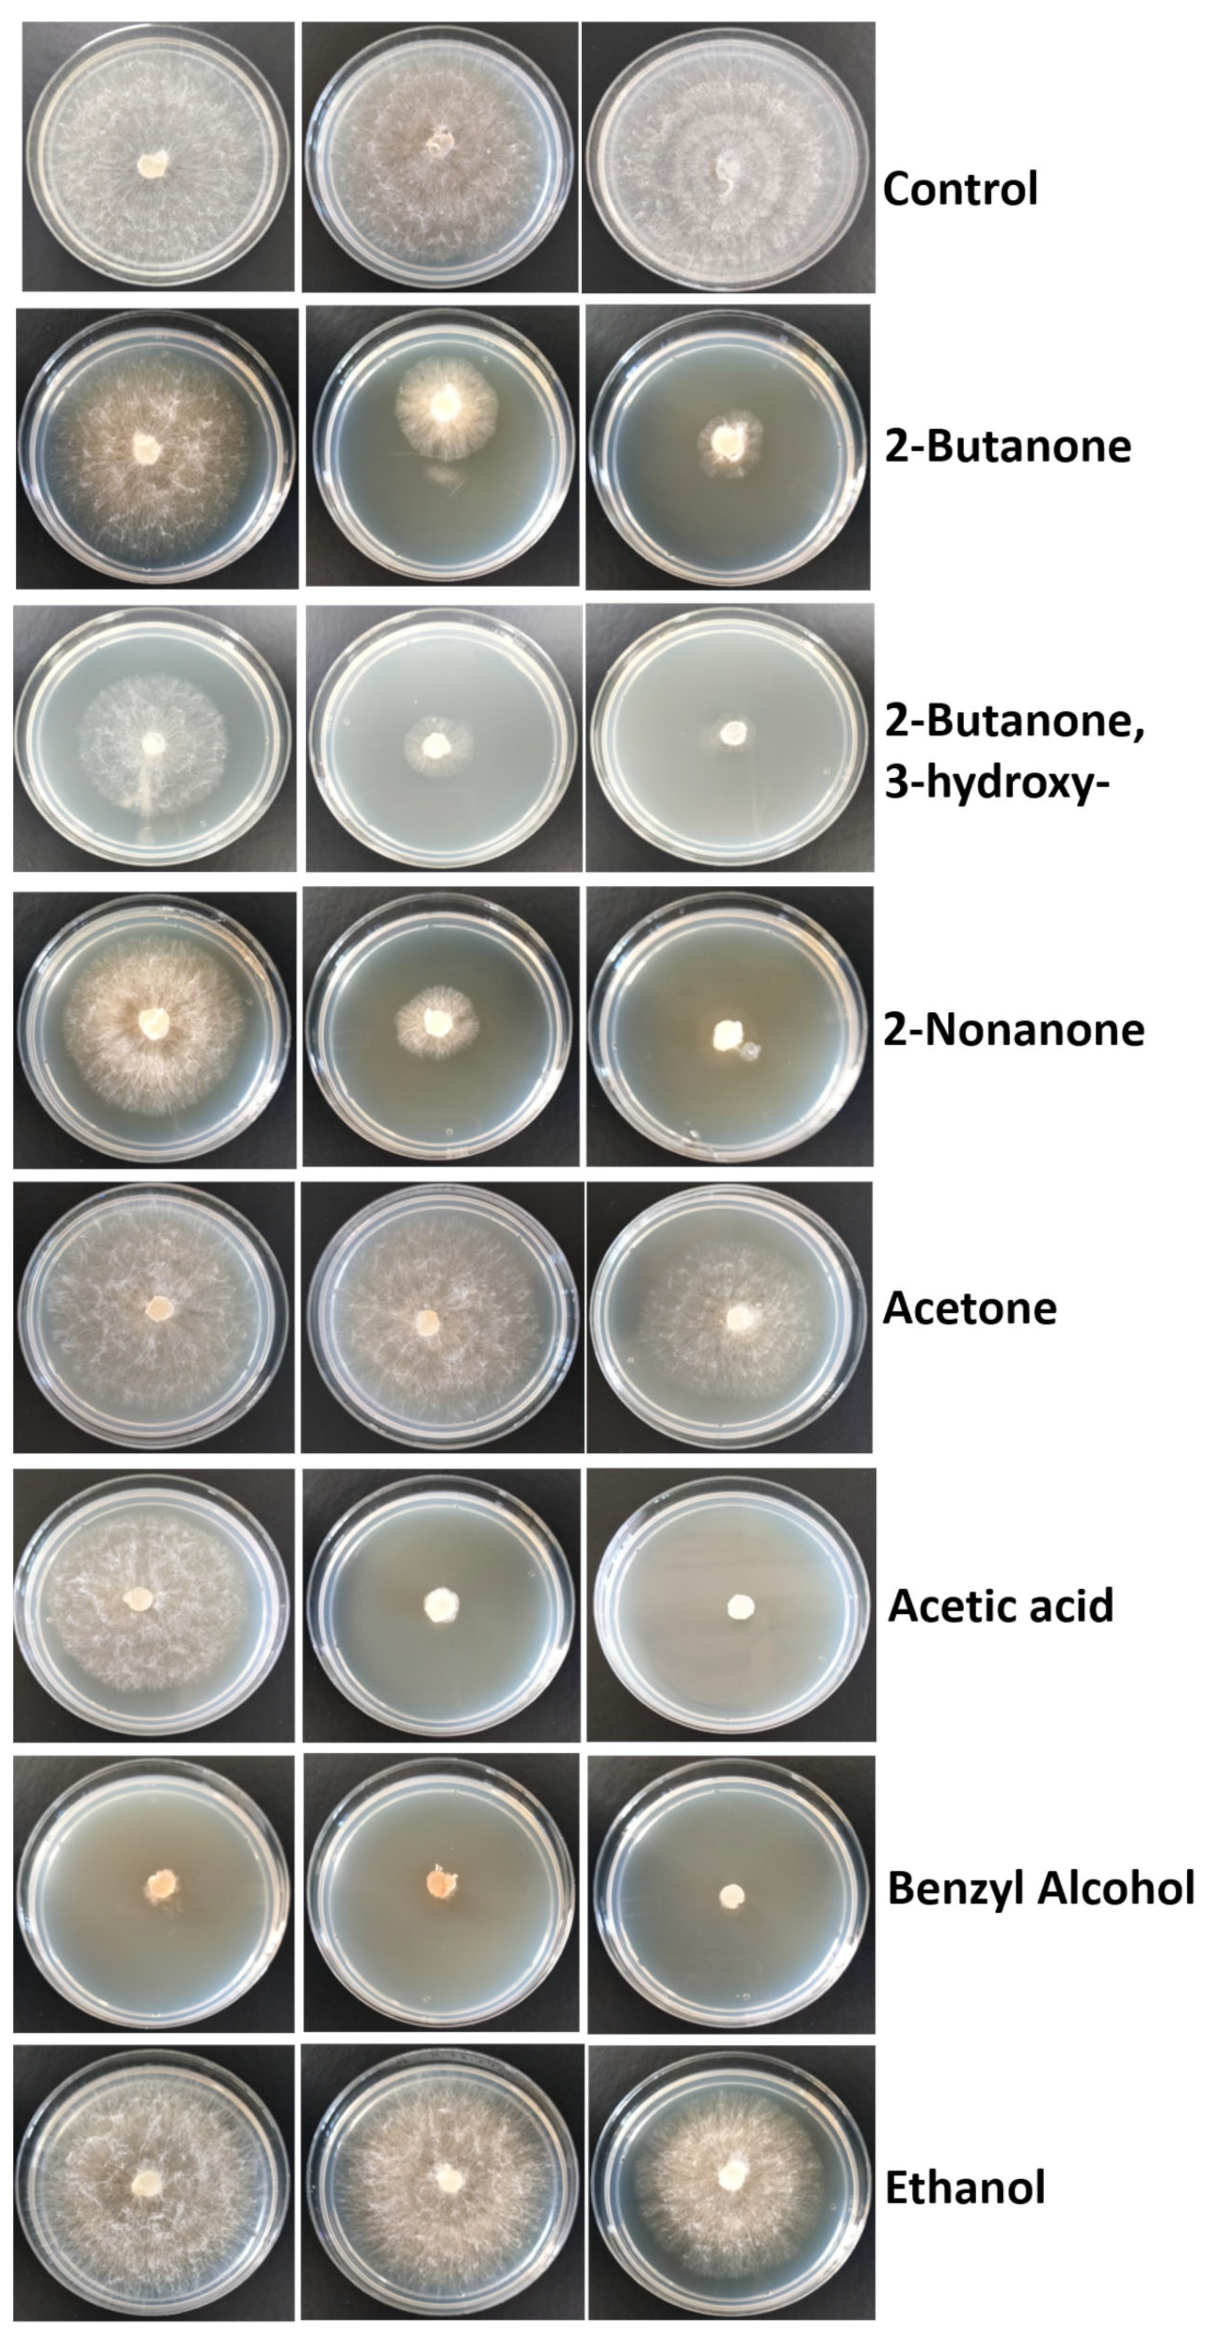

Volatile Organic Compounds Produced by Kosakonia cowanii Cp1 Isolated from the Seeds of Capsicum pubescens R & P Possess Antifungal Activity
Abstract
1. Introduction
2. Materials and Methods
2.1. Bacterial Strain Isolation
2.2. Pathogenicity Test
2.3. Genome Sequencing and Assembly
2.4. Antibiotic Susceptibility Testing
2.5. Inhibitory Effects of VOCs
2.6. HS-SPME-GC–MS Analysis of VOCs
3. Results
3.1. Isolation of K. cowanii from Capsicum pubescens Seeds
3.2. General Genome and the Plasmid Features of K. cowanii Strain Cp1
3.3. Effects of VOCs on Mycelial Growth
3.4. Characterization of VOCs
3.5. Evaluation of Standard VOCs
4. Discussion
Supplementary Materials
Author Contributions
Funding
Data Availability Statement
Conflicts of Interest
References
- Kraft, K.H.; Brown, C.H.; Nabhan, G.P.; Luedeling, E.; de Luna Ruiz, J.; Coppens d’Eeckenbrugge, G.; Hijmans, R.J.; Gepts, P. Multiple lines of evidence for the origin of domesticated chili pepper, Capsicum annuum, in Mexico. Proc. Natl. Acad. Sci. USA 2014, 111, 6165–6170. [Google Scholar] [CrossRef] [PubMed]
- Tripodi, P.; Rabanus-Wallace, M.T.; Barchi, L.; Kale, S.; Esposito, S.; Acquadro, A.; Schafleitner, R.; van Zonneveld, M.; Prohens, J.; Diez, M.J.; et al. Global range expansion history of pepper (Capsicum spp.) revealed by over 10,000 genebank accessions. Proc. Natl. Acad. Sci. USA 2021, 118, e2104315118. [Google Scholar] [CrossRef]
- Swamy, K.R.M. Origin, distribution, taxonomy, botanical description, genetic diversity and breeding of capsicum (Capsicum annuum L.). Int. J. Dev. Res. 2023, 13, 61956–61977. [Google Scholar]
- McCoy, J.; Martínez-Ainsworth, N.; Bernau, V.; Scheppler, H.; Hedblom, G.; Adhikari, A.; McCormick, A.; Kantar, M.; McHale, L.; Jardón-Barbolla, L.; et al. Population structure in diverse pepper (Capsicum spp.) accessions. BMC Res. Notes 2023, 16, 20. [Google Scholar] [CrossRef]
- Pereira-Dias, L.; Vilanova, S.; Fita, A.; Prohens, J.; Rodríguez-Burruezo, A. Genetic diversity, population structure, and relationships in a collection of pepper (Capsicum spp.) landraces from the Spanish centre of diversity revealed by genotyping-by-sequencing (GBS). Hortic. Res. 2019, 6, 54. [Google Scholar] [CrossRef]
- Zhang, X.-m.; Zhang, Z.-h.; Gu, X.-z.; Mao, S.-l.; Li, X.; Chadœuf, J.; Palloix, A.; Wang, L.-h.; Zhang, B.-x. Genetic diversity of pepper (Capsicum spp.) germplasm resources in China reflects selection for cultivar types and spatial distribution. J. Integr. Agric. 2016, 15, 1991–2001. [Google Scholar] [CrossRef]
- Sarath Babu, B.; Pandravada, S.R.; Pasada Rao, R.D.V.J.; Anitha, K.; Chakrabarty, S.K.; Varaprasad, K.S. Global sources of pepper genetic resources against arthropods, nematodes and pathogens. Crop Prot. 2011, 30, 389–400. [Google Scholar] [CrossRef]
- Ros, C.; Lacasa, C.M.; Martínez, V.; Bielza, P.; Lacasa, A. Response of pepper rootstocks to co-infection of Meloidogyne incognita and Phytophthora spp. Eur. J. Hortic. Sci. 2014, 79, 22–28. [Google Scholar]
- Özkaynak, E.; Devran, Z.; Kahveci, E.; Doğanlar, S.; Başköylü, B.; Doğan, F.; Yüksel, M. Pyramiding multiple genes for resistance to PVY, TSWV and PMMoV in pepper using molecular markers. Eur. J. Hortic. Sci. 2014, 79, 233–239. [Google Scholar]
- Parisi, M.; Alioto, D.; Tripodi, P. Overview of Biotic Stresses in Pepper (Capsicum spp.): Sources of Genetic Resistance, Molecular Breeding and Genomics. Int. J. Mol. Sci. 2020, 21, 2587. [Google Scholar] [CrossRef]
- Lozada, D.N.; Bosland, P.W.; Barchenger, D.W.; Haghshenas-Jaryani, M.; Sanogo, S.; Walker, S. Chile Pepper (Capsicum) Breeding and Improvement in the “Multi-Omics” Era. Front. Plant Sci. 2022, 13, 879182. [Google Scholar] [CrossRef]
- Kim, T.J.; Hyeon, H.; Park, N.I.; Yi, T.G.; Lim, S.H.; Park, S.Y.; Ha, S.H.; Kim, J.K. A high-throughput platform for interpretation of metabolite profile data from pepper (Capsicum) fruits of 13 phenotypes associated with different fruit maturity states. Food Chem. 2020, 331, 127286. [Google Scholar] [CrossRef] [PubMed]
- Vijay, A.; Kumar, A.; Islam, K.; Momo, J.; Ramchiary, N. Functional genomics to understand the tolerance mechanism against biotic and abiotic stresses in Capsicum species. In Transcriptome Profiling; Academic Press: Cambridge, MA, USA, 2023; pp. 305–332. [Google Scholar]
- Zhang, L.; Qin, C.; Mei, J.; Chen, X.; Wu, Z.; Luo, X.; Cheng, J.; Tang, X.; Hu, K.; Li, S.C. Identification of microRNA targets of Capsicum spp. using miRTrans—A trans-omics approach. Front. Plant Sci. 2017, 8, 495. [Google Scholar] [CrossRef][Green Version]
- Reimer, J.J.; Shaaban, B.; Drummen, N.; Sanjeev Ambady, S.; Genzel, F.; Poschet, G.; Wiese-Klinkenberg, A.; Usadel, B.; Wormit, A. Capsicum leaves under stress: Using multi-omics analysis to detect abiotic stress network of secondary metabolism in two species. Antioxidants 2022, 11, 671. [Google Scholar] [CrossRef] [PubMed]
- Jonkers, W.; Gundel, P.E.; Verma, S.K.; White, J.F. (Eds.) Seed Microbiome Research; Frontiers Media SA: Lausanne, Switzerland, 2022. [Google Scholar]
- Tkalec, V.; Mahnic, A.; Gselman, P.; Rupnik, M. Analysis of seed-associated bacteria and fungi on staple crops using the cultivation and metagenomic approaches. Folia Microbiol. 2022, 67, 351–361. [Google Scholar] [CrossRef] [PubMed]
- Dowarah, B.; Agarwal, H.; Krishnatreya, D.B.; Sharma, P.L.; Kalita, N.; Agarwala, N. Evaluation of seed associated endophytic bacteria from tolerant chilli cv. Firingi Jolokia for their biocontrol potential against bacterial wilt disease. Microbiol. Res. 2021, 248, 126751. [Google Scholar] [CrossRef]
- Jeong, S.; Kim, T.M.; Choi, B.; Kim, Y.; Kim, E. Invasive Lactuca serriola seeds contain endophytic bacteria that contribute to drought tolerance. Sci. Rep. 2021, 11, 13307. [Google Scholar] [CrossRef]
- Jan-Roblero, J.; Cruz-Maya, J.A.; Barajas, C.G. Chapter 12—Kosakonia. In Beneficial Microbes in Agro-Ecology; Amaresan, N., Annapurna, K., Sankaranarayanan, A., Kumar, M.S., Kumar, K., Eds.; Academic Press: Cambridge, MA, USA, 2020; pp. 213–231. [Google Scholar]
- Romano, I.; Ventorino, V.; Ambrosino, P.; Testa, A.; Chouyia, F.E.; Pepe, O. Development and Application of Low-Cost and Eco-Sustainable Bio-Stimulant Containing a New Plant Growth-Promoting Strain Kosakonia pseudosacchari TL13. Front. Microbiol. 2020, 11, 2044. [Google Scholar] [CrossRef]
- Yang, X.-J.; Wang, S.; Cao, J.M.; Hou, J.H. Complete genome sequence of human pathogen Kosakonia cowanii type strain 888-76. Braz. J. Micro-Biol. 2018, 49, 16–17. [Google Scholar] [CrossRef]
- Bhatti, M.D.; Kalia, A.; Sahasrabhojane, P.; Kim, J.; Greenberg, D.E.; Shelburne, S.A. Identification and Whole Genome Sequencing of the First Case of Kosakonia radicincitans Causing a Human Blood-stream Infection. Front. Microbiol. 2017, 8, 62. [Google Scholar] [CrossRef]
- Berinson, B.; Bellon, E.; Christner, M.; Both, A.; Aepfelbacher, M.; Rohde, H. Identification of Kosakonia cowanii as a rare cause of acute cholecystitis: Case report and review of the literature. BMC Infect. Dis. 2020, 20, 366. [Google Scholar] [CrossRef]
- Zhang, Y.; Wang, B.; Li, Q.; Huang, D.; Zhang, Y.; Li, G.; He, H. Isolation and Complete Genome Sequence Analysis of Kosakonia cowanii Pa82, a Novel Pathogen Causing Bacterial Wilt on Patchouli. Front. Microbiol. 2022, 12, 818228. [Google Scholar] [CrossRef]
- Krawczyk, K.; Borodynko-Filas, N. Kosakoniacowanii as the New Bacterial Pathogen Affecting Soybean (Glycine max Willd.). Eur. J. Plant Pathol. 2020, 157, 173–183. [Google Scholar] [CrossRef]
- Brady, C.L.; Venter, S.N.; Cleenwerck, I.; Engelbeen, K.; de Vos, P.; Wingfield, M.J.; Telechea, N.; Coutinho, T.A. Isolation of Enterobacter cowanii from Eucalyptus showing symptoms of bacterial blight and dieback in Uruguay. Lett. Appl. Microbiol. 2009, 49, 461–465. [Google Scholar] [CrossRef]
- Furtado, G.Q.; Guimarães, L.M.S.; Lisboa, D.O.; Cavalcante, G.P.; Arriel, D.A.A.; Alfenas, A.C.; Oliveira, J.R. First Report of Enterobacter cowanii Causing Bacterial Spot on Mabea fistulifera, a Native Forest Species in Brazil. Plant Dis. 2012, 96, 1576. [Google Scholar] [CrossRef] [PubMed]
- Petrzik, K.; Brázdová, S.; Krawczyk, K. Novel Viruses That Lyse Plant and Human Strains of Kosakonia cowanii. Viruses 2021, 13, 1418. [Google Scholar] [CrossRef]
- Dennison, N.J.; Jupatanakul, N.; Dimopoulos, G. The mosquito microbiota influences vector competence for human pathogens. Curr. Opin. Insect Sci. 2014, 3, 6–13. [Google Scholar] [CrossRef]
- Hernández Gómez, Y.F.; González Espinosa, J.; Ramos López, M.Á.; Arvizu Gómez, J.L.; Saldaña, C.; Rodríguez Morales, J.A.; García Gutiérrez, M.C.; Pérez Moreno, V.; Álvarez Hidalgo, E.; Nuñez Ramírez, J.; et al. Insights into the Bacterial Diversity and Detection of Opportunistic Pathogens in Mexican Chili Pow-der. Microorganisms 2022, 10, 1677. [Google Scholar] [CrossRef] [PubMed]
- González Espinosa, J.; Hernández Gómez, Y.F.; Javier Martínez, Y.; Flores Gallardo, F.J.; Pacheco Aguilar, J.R.; Ramos López, M.Á.; Arvizu Gómez, J.L.; Saldaña Gutierrez, C.; Rodríguez Morales, J.A.; García Gutiérrez, M.C.; et al. Kosakonia cowanii Ch1 Isolated from Mexican Chili Powder Reveals Growth Inhibition of Phytopathogenic Fungi. Microorganisms 2023, 11, 1758. [Google Scholar] [CrossRef] [PubMed]
- Aguilar-Rincón, V.H.; Corona Torres, P.T.; López López, L.; Latournerie Moreno, M.; Ramírez Meraz, H.; Villalón Mendoza, Y.J.; Aguilar Castillo, A. Los Chiles de México y su Distribución; Rev Fitotecnia Mex SINAREFI, Colegio de Postgraduados; INIFAP, ITConkal, UANL, UAN; Sociedad Mexicana de Fitogenética A.C.: Montecillo, Texcoco, México, 2010; p. 114. [Google Scholar]
- Saitou, N.; Nei, M. The neighbor-joining method: A new method for reconstructing phylogenetic trees. Mol. Biol. Evol. 1987, 4, 406–425. [Google Scholar]
- Felsenstein, J. Confidence Limits on Phylogenies: An Approach Using the Bootstrap. Evolution 1985, 39, 783–791. [Google Scholar] [CrossRef] [PubMed]
- Jukes, T.H.; Cantor, C.R. Evolution of protein molecules. In Mammalian Protein Metabolism; Munro, H.N., Ed.; Academic Press: Cambridge, MA, USA, 1969; pp. 21–132. [Google Scholar]
- Kumar, S.; Stecher, G.; Li, M.; Knyaz, C.; Tamura, K. MEGA X: Molecular Evolutionary Genetics Analysis across Computing Platforms. Mol. Biol. Evol. 2018, 35, 1547–1549. [Google Scholar] [CrossRef] [PubMed]
- Olson, R.D.; Assaf, R.; Brettin, T.; Conrad, N.; Cucinell, C.; Davis, J.J.; Dempsey, D.M.; Dickerman, A.; Dietrich, E.M.; Kenyon, R.W.; et al. Introducing the Bacterial Viral Bioinformatics Resource Center (BV-BRC): A resource combining PATRIC, IRD and ViPR. Nucleic Acids Res. 2022, 51, D678–D689. [Google Scholar] [CrossRef] [PubMed]
- Brettin, T.; Davis, J.J.; Disz, T.; Edwards, R.A.; Gerdes, S.; Olsen, G.J.; Olson, R.; Overbeek, R.; Parrello, B.; Pusch, G.D.; et al. RASTtk: A modular and extensible implementation of the RAST algorithm for building custom annotation pipelines and annotating batches of genomes. Sci. Rep. 2015, 5, 8365. [Google Scholar] [CrossRef] [PubMed]
- Naquin, D.; d’Aubenton-Carafa, Y.; Thermes, C.; Silvain, M. CIRCUS: A package for Circos display of structural genome variations from paired-end and mate-pair sequencing data. BMC Bioinform. 2014, 15, 198. [Google Scholar] [CrossRef]
- Ondov, B.D.; Treangen, T.J.; Melsted, P.; Mallonee, A.B.; Bergman, N.H.; Koren, S.; Phillippy, A.M. Mash: Fast genome and metagenome distance estimation using MinHash. Genome Biol. 2016, 17, 132. [Google Scholar] [CrossRef]
- Dmitry, A.; Mikhail, R.; Alla, L.; Pevzner, P.A. Plasmid detection and assembly in genomic and metagenomic data sets. Genome Res. 2019, 29, 961–968. [Google Scholar]
- Clinical and Laboratory Standards Institute. Performance Standards for Antimicrobial Disk Susceptibility Tests, approved standard, 12th ed.; Clinical and Laboratory Standards Institute: Wayne, PA, USA, 2018. [Google Scholar]
- Escalera-Ordaz, A.K.; Guillén-Andrade, H.; Lara-Chávez, M.B.N.; Lemus-Flores, C.; Rodríguez-Carpena, J.G.; Valdivia-Bernal, R. Characterization of cultivated varieties of Capsicum pubescens in Michoacán, Mexico. Rev. Mex. Cienc. Agríc. 2019, 10, 239–251. [Google Scholar]
- Meckelmann, S.W.; Jansen, C.; Riegel, D.W.; van Zonneveld, M.; Ríos, L.; Peña, K.; Mueller-Seitz, E.; Petz, M. Phytochemicals in Native Peruvian Capsicum pubescens (Rocoto). Eur. Food Res. Technol. 2015, 241, 817–825. [Google Scholar] [CrossRef]
- Romero-Luna, H.E.; Colina, J.; Guzmán-Rodríguez, L.; Sierra-Carmona, C.G.; Farías-Campomanes, Á.M.; García-Pinilla, S.; González-Tijera, M.M.; Malagón-Alvira, K.O.; Peredo-Lovillo, A. Capsicum fruits as functional ingredients with antimicrobial activity: An emphasis on mechanisms of action. J. Food Sci. Technol. 2022, 60, 1–11. [Google Scholar] [CrossRef]
- Nishino, K.; Latifi, T.; Groisman, E.A. Virulence and drug resistance roles of multidrug efflux systems of Salmonella enterica serovar Typhimurium. Mol. Microbiol. 2006, 59, 126–141. [Google Scholar] [CrossRef]
- Pletzer, D.; Weingart, H. Characterization and regulation of the resistance-nodulation-cell division-type multidrug efflux pumps MdtABC and MdtUVW from the fire blight pathogen Erwinia amylovora. BMC Microbiol. 2014, 14, 185. [Google Scholar] [CrossRef]
- Abi Khattar, Z.; Lanois, A.; Hadchity, L.; Gaudriault, S.; Givaudan, A. Spatiotemporal expression of the putative MdtABC efflux pump of Phtotorhabdus luminescens occurs in a protease-dependent manner during insect infection. PLoS ONE 2019, 14, e0212077. [Google Scholar] [CrossRef] [PubMed]
- Hirakawa, H.; Inazumi, Y.; Masaki, T.; Hirata, T.; Yamaguchi, A. Indole induces the expression of multidrug exporter genes in Escherichia coli. Mol. Microbiol. 2005, 55, 1113–1126. [Google Scholar] [CrossRef]
- Nishino, K.; Nikaido, E.; Yamaguchi, A. Regulation of multidrug efflux systems involved in multidrug and metal resistance of Salmonella enterica serovar Typhimurium. J. Bacteriol. 2007, 189, 9066–9075. [Google Scholar] [CrossRef]
- Larsson, D.G.J.; Flach, C.F. Antibiotic resistance in the environment. Nat. Rev. Microbiol. 2022, 20, 257–269. [Google Scholar] [CrossRef] [PubMed]
- Koch, N.; Islam, N.F.; Sonowal, S.; Prasad, R.; Sarma, H. Environmental antibiotics and resistance genes as emerging contaminants: Methods of detection and bioremediation. Curr. Res. Microb. Sci. 2021, 2, 100027. [Google Scholar] [CrossRef] [PubMed]
- Chowdhury, N.; Suhani, S.; Purkaystha, A.; Begum, M.K.; Raihan, T.; Alam, M.J.; Islam, K.; Azad, A.K. Identification of AcrAB-TolC Efflux Pump Genes and Detection of Mutation in Efflux Repressor AcrR from Omeprazole Responsive Multidrug-Resistant Escherichia coli Isolates Causing Urinary Tract Infections. Microbiol. Insights 2019, 12, 1178636119889629. [Google Scholar] [CrossRef]
- Yousefian, N.; Ornik-Cha, A.; Poussard, S.; Decossas, M.; Berbon, M.; Daury, L.; Taveau, J.C.; Dupuy, J.W.; Đorđević-Marquardt, S.; Lambert, O.; et al. Structural characterization of the EmrAB-TolC efflux complex from E. coli. Biochim. Biophys. Acta Biomembr. 2021, 1863, 183488. [Google Scholar] [CrossRef]
- Lu, S.; Zgurskaya, H.I. MacA, a periplasmic membrane fusion protein of the macrolide transporter MacAB-TolC, binds lipopolysaccharide core specifically and with high affinity. J. Bacteriol. 2013, 195, 4865–4872. [Google Scholar] [CrossRef]
- Swick, M.C.; Morgan-Linnell, S.K.; Carlson, K.M.; Zechiedrich, L. Expression of multidrug efflux pump genes acrAB-tolC, mdfA, and norE in Escherichia coli clinical isolates as a function of fluoroquinolone and multidrug resistance. Antimicrob. Agents Chemother. 2011, 55, 921–924. [Google Scholar] [CrossRef] [PubMed]
- Moreno, R.; Rojo, F. The importance of understanding the regulation of bacterial metabolism. Environ. Microbiol. 2023, 25, 54–58. [Google Scholar] [CrossRef] [PubMed]
- Almeida, O.A.C.; de Araujo, N.O.; Dias, B.H.S.; de Sant’Anna Freitas, C.; Coerini, L.F.; Ryu, C.-M.; de Castro Oliveira, J.V. The power of the smallest: The inhibitory activity of microbial volatile organic compounds against phytopathogens. Front. Microbiol. 2023, 13, 951130. [Google Scholar] [CrossRef]
- Marquez-Villavicencio, M.d.P.; Weber, B.; Witherell, R.A.; Willis, D.K.; Charkowski, A.O. The 3-Hydroxy-2-Butanone Pathway Is Required for Pectobacterium carotovorum Pathogenesis. PLoS ONE 2011, 6, e22974. [Google Scholar] [CrossRef]
- Ryu, C.M.; Farag, M.A.; Hu, C.H.; Reddy, M.S.; Wei, H.X.; Paré, P.W.; Kloepper, J.W. Bacterial volatiles promote growth in Arabidopsis. Proc. Natl. Acad. Sci. USA 2003, 100, 4927–4932. [Google Scholar] [CrossRef] [PubMed]
- Ryu, C.-M.; Farag, M.A.; Hu, C.-H.; Reddy, M.S.; Kloepper, J.W.; Paré, P.W. Bacterial Volatiles Induce Systemic Resistance in Arabidopsis. Plant Physiol. 2004, 134, 1017–1026. [Google Scholar] [CrossRef]
- Cho, S.M.; Kang, B.R.; Han, S.H.; Anderson, A.J.; Park, J.-Y.; Lee, Y.-H.; Cho, B.H.; Yang, K.-Y.; Ryu, C.-M.; Kim, Y.C. 2R,3R-Butanediol, a Bacterial Volatile Produced by Pseudomonas chlororaphis O6, Is Involved in Induction of Systemic Tolerance to Drought in Arabidopsis thaliana. Mol. Plant Microbe Interact. 2008, 21, 1067–1075. [Google Scholar] [CrossRef]
- Zhao, X.; Zhou, J.; Tian, R.; Liu, Y. Microbial volatile organic compounds: Antifungal mechanisms, applications, and challenges. Front. Microbiol. 2022, 13, 922450. [Google Scholar] [CrossRef]
- Lemfack, M.C.; Gohlke, B.-O.; Toguem, S.M.T.; Preissner, S.; Piechulla, B.; Preissner, R. mVOC 2.0: A database of microbial volatiles. Nucleic Acids Res. 2017, 46, D1261–D1265. [Google Scholar] [CrossRef] [PubMed]

| Virulence Factor Classification | Gene Name | Putative Function |
|---|---|---|
| Endotoxin | gtrB | Bactoprenol glucosyl transferase |
| Iron uptake, siderophore | entA | 2,3-dihydro-2,3-dihydroxybenzoate dehydrogenase 2,3-dihydro-2,3-dihydroxybenzoate dehydrogenase of siderophore biosynthesis |
| entB | Isochorismatase of siderophore biosynthesis | |
| fepB | Ferric enterobactin-binding periplasmic protein FepB | |
| fepC | Ferric enterobactin transport ATP-binding protein FepC | |
| fepD | Ferric enterobactin transport system permease protein FepD | |
| fepG | Ferric enterobactin transport system permease protein FepG | |
| entS | Enterobactin exporter EntS | |
| Secretion system, invasion, motility | flgC | Flagellar basal-body rod protein FlgC |
| motA | Flagellar motor rotation protein MotA | |
| flgH | Flagellar L-ring protein FlgH | |
| flgB | Flagellar basal-body rod protein FlgB | |
| flgG | Flagellar basal-body rod protein FlgG | |
| fliG | Flagellar motor switch protein FliG | |
| fliP | Flagellar biosynthesis protein FliP | |
| cheY | Chemotaxis regulator; transmits chemoreceptor signals to flagellar motor components CheY | |
| cheW | Positive regulator of CheA protein activity (CheW) | |
| fliM | Flagellar motor switch protein FliM | |
| fliC | Flagellin FliC | |
| fliA | RNA polymerase sigma factor for flagellar operon |
| Compounds | Retention Time (min) | Relative Peak Area (%) | Chemical Classes | Compounds | Retention Time (min) | Relative Peak Area (%) | Chemical Classes |
|---|---|---|---|---|---|---|---|
| Carbon dioxide | 4.041 | 1.81 | Hydrocarbons | 1-Hexanol, 2-ethyl- | 39.459 | 2.22 | Alcohols |
| Ethyl ether | 4.466 | 0.70 | Esters | ||||
| Methanethiol | 4.703 | 0.42 | Alcohols | Benzaldehyde | 40.287 | 0.94 | Aldehydes |
| Acetaldehyde | 4.854 | 0.54 | Aldehydes | 1-Octanol | 42.356 | 1.62 | Alcohols |
| Acetone | 6.176 | 0.61 | Ketones | 2-Undecanone | 44.335 | 1.12 | Ketones |
| Butanal | 7.610 | 0.32 | Aldehydes | 2-Acetylthiazole | 45.502 | 0.54 | Other compounds |
| Ethyl Acetate | 8.037 | 0.29 | Esters | Acetophenone | 45.741 | 0.74 | Ketones |
| 2-Butanone | 8.337 | 0.90 | Ketones | Pyrazine, 2,5-dimethyl-3-(3-methylbutyl)- | 46.713 | 0.55 | Pyrazine |
| Butanal, 3-methyl- | 9.088 | 0.23 | Aldehydes | Acetic acid, decyl ester | 48.558 | 0.77 | Esters |
| Ethanol | 9.566 | 5.56 | Alcohols | 4,4-Dimethyl-2-cyclopenten-1-one | 49.412 | 0.08 | Other compounds |
| 2,3-Butanedione | 12.247 | 2.58 | Ketones | Cyclodecane | 53.105 | 3.10 | Hydrocarbons |
| Trichloroethylene | 12.871 | 0.21 | Other compounds | 2-Tridecanone | 57.172 | 1.25 | Ketones |
| Trichloromethane | 14.529 | 0.33 | Other compounds | 3-Decen-1-ol, acetate, (Z)- | 58.325 | 1.20 | Alcohols |
| Toluene | 15.273 | 0.30 | Hydrocarbons | Benzyl alcohol | 60.204 | 0.68 | Alcohols |
| Disulfide, dimethyl | 16.91 | 1.35 | Other compounds | Butanoic acid, butyl ester | 62.141 | 4.54 | Esters |
| p-Xylene | 21.171 | 0.12 | Other compounds | Propanoic acid, 2-methyl-, 2,2-dimethyl-1-(2-hydroxy-1-methylethyl)propyl ester | 63.486 | 2.12 | Esters |
| 1-Butanol | 21.744 | 1.42 | Alcohols | Phenylethyl Alcohol | 63.944 | 1.99 | Alcohols |
| Ethanol, 2-methoxy- | 23.279 | 0.95 | Alcohols | Ethanol, 2,2′-oxybis- | 68.575 | 0.51 | Alcohols |
| 2-Heptanone | 24.063 | 0.26 | Ketones | Cyclododecane | 71.619 | 4.29 | Hydro-carbons |
| 1,3-Diazine | 24.981 | 0.48 | Other compounds | 2-Propenal, 3-phenyl- | 73.169 | 0.28 | Aldehydes |
| 1-Butanol, 3-methyl- | 25.259 | 4.83 | Alcohols | 2-Nonadecanone | 74.724 | 0.58 | Ketones |
| Pyrazine, methyl- | 27.947 | 1.15 | Pyrazine | Octanoic Acid | 76.216 | 0.68 | Acids |
| 2-Butanone, 3-hydroxy- | 29.244 | 13.52 | Ketones | Triacetin | 76.667 | 0.84 | Other compounds |
| 2-Propanone, 1-hydroxy- | 29.817 | 0.09 | Ketones | 2,4,7,9-Tetramethyl-5-decyn-4,7-diol | 78.388 | 1.90 | Alcohols |
| Pyrazine, 2,5-dimethyl- | 30.931 | 6.47 | Pyrazine | Benzoic acid, 4-tert-butyl-, 3,5-dichloro-4-pyridyl ester | 79.388 | 0.19 | Esters |
| Pyrazine, 2,6-dimethyl- | 31.245 | 0.27 | Pyrazine | Benzoic acid, 2-amino-, methyl ester | 83.037 | 0.12 | Esters |
| 1-Hexanol | 32.875 | 0.20 | Alcohols | ||||
| Dimethyl trisulfide | 33.789 | 0.20 | Other compounds | Methyl 8-methyl-nonanoate | 84.445 | 0.51 | Esters |
| Pyrazine, 2-ethyl-6-methyl- | 34.218 | 0.12 | Pyrazine | Hexanedioic acid, dibutyl ester | 85.423 | 0.44 | Esters |
| Pyrazine, 2-ethyl-5-methyl- | 34.484 | 0.43 | Pyrazine | Dodecanoic acid, 3-hydroxy- | 85.693 | 1.13 | Acids |
| 2-Nonanone | 34.997 | 1.32 | Ketones | Diethyl phthalate | 88.452 | 0.39 | Other compounds |
| Pyrazine, 2-methyl-5-(1-methylethyl)- | 35.597 | 0.14 | Pyrazine | Indole | 90.108 | 0.11 | Aromatics |
| Pyrazine, 3-ethyl-2,5-dimethyl- | 37.062 | 1.30 | Pyrazine | Phthalic acid, hex-2-yn-4-yl isobutyl ester | 95.053 | 1.10 | Other compounds |
| Octanoic acid, ethyl ester | 37.407 | 0.43 | Esters | ||||
| Acetic acid, octyl ester | 39.183 | 0.21 | Esters |
Disclaimer/Publisher’s Note: The statements, opinions and data contained in all publications are solely those of the individual author(s) and contributor(s) and not of MDPI and/or the editor(s). MDPI and/or the editor(s) disclaim responsibility for any injury to people or property resulting from any ideas, methods, instructions or products referred to in the content. |
© 2023 by the authors. Licensee MDPI, Basel, Switzerland. This article is an open access article distributed under the terms and conditions of the Creative Commons Attribution (CC BY) license (https://creativecommons.org/licenses/by/4.0/).
Share and Cite
Hernández Flores, J.L.; Martínez, Y.J.; Ramos López, M.Á.; Saldaña Gutierrez, C.; Reyes, A.A.; Armendariz Rosales, M.M.; Cortés Pérez, M.J.; Mendoza, M.F.; Ramírez Ramírez, J.; Zavala, G.R.; et al. Volatile Organic Compounds Produced by Kosakonia cowanii Cp1 Isolated from the Seeds of Capsicum pubescens R & P Possess Antifungal Activity. Microorganisms 2023, 11, 2491. https://doi.org/10.3390/microorganisms11102491
Hernández Flores JL, Martínez YJ, Ramos López MÁ, Saldaña Gutierrez C, Reyes AA, Armendariz Rosales MM, Cortés Pérez MJ, Mendoza MF, Ramírez Ramírez J, Zavala GR, et al. Volatile Organic Compounds Produced by Kosakonia cowanii Cp1 Isolated from the Seeds of Capsicum pubescens R & P Possess Antifungal Activity. Microorganisms. 2023; 11(10):2491. https://doi.org/10.3390/microorganisms11102491
Chicago/Turabian StyleHernández Flores, José Luis, Yomaiko Javier Martínez, Miguel Ángel Ramos López, Carlos Saldaña Gutierrez, Aldo Amaro Reyes, Mariem Monserrat Armendariz Rosales, Maraly Jazmin Cortés Pérez, Mayela Fosado Mendoza, Joanna Ramírez Ramírez, Grecia Ramírez Zavala, and et al. 2023. "Volatile Organic Compounds Produced by Kosakonia cowanii Cp1 Isolated from the Seeds of Capsicum pubescens R & P Possess Antifungal Activity" Microorganisms 11, no. 10: 2491. https://doi.org/10.3390/microorganisms11102491
APA StyleHernández Flores, J. L., Martínez, Y. J., Ramos López, M. Á., Saldaña Gutierrez, C., Reyes, A. A., Armendariz Rosales, M. M., Cortés Pérez, M. J., Mendoza, M. F., Ramírez Ramírez, J., Zavala, G. R., Tovar Becerra, P. L., Valdez Santoyo, L., Villasana Rodríguez, K., Rodríguez Morales, J. A., & Campos Guillén, J. (2023). Volatile Organic Compounds Produced by Kosakonia cowanii Cp1 Isolated from the Seeds of Capsicum pubescens R & P Possess Antifungal Activity. Microorganisms, 11(10), 2491. https://doi.org/10.3390/microorganisms11102491

